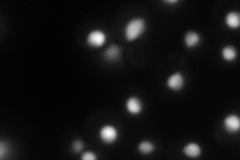
YJR060W
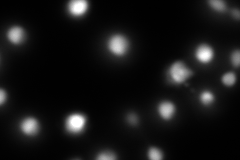
YJR060W
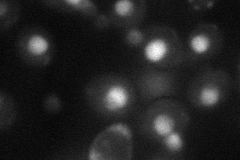
YJR060W
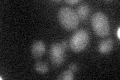
YJR060W

View description
Helix-loop-helix protein that binds the motif CACRTG, which is present at several sites including MET gene promoters and centromere DNA element I (CDEI); required for nucleosome positioning at this motif; targets Isw1p to DNA
Localization:
Intensity:
Fold change:
Significance:
-
C’ GFP library in SD

below threshold16.1 -
N' NOP1pr-GFP in SD
nucleus,nucleolus99.6793 -
N' TEF2pr-mCherry in SD
nucleus,nucleolus83.2672 -
N' NATIVEpr-GFP in SD

nucleus59.7032 -
N' TEF2pr-VC and Cyto-VN in SD
nucleus43.4536 -
C’ GFP library in SD+DTT

cytosol16.251No -
C’ GFP library in SD+H2O2

cytosol171.05No -
C’ GFP library in Starvation Media
cytosol23.671.47No -
C’ GFP library on the background of Pup2-DaMP

below threshold -
C’ GFP library on the background of CCT mutant

below threshold16.92951.05107No
